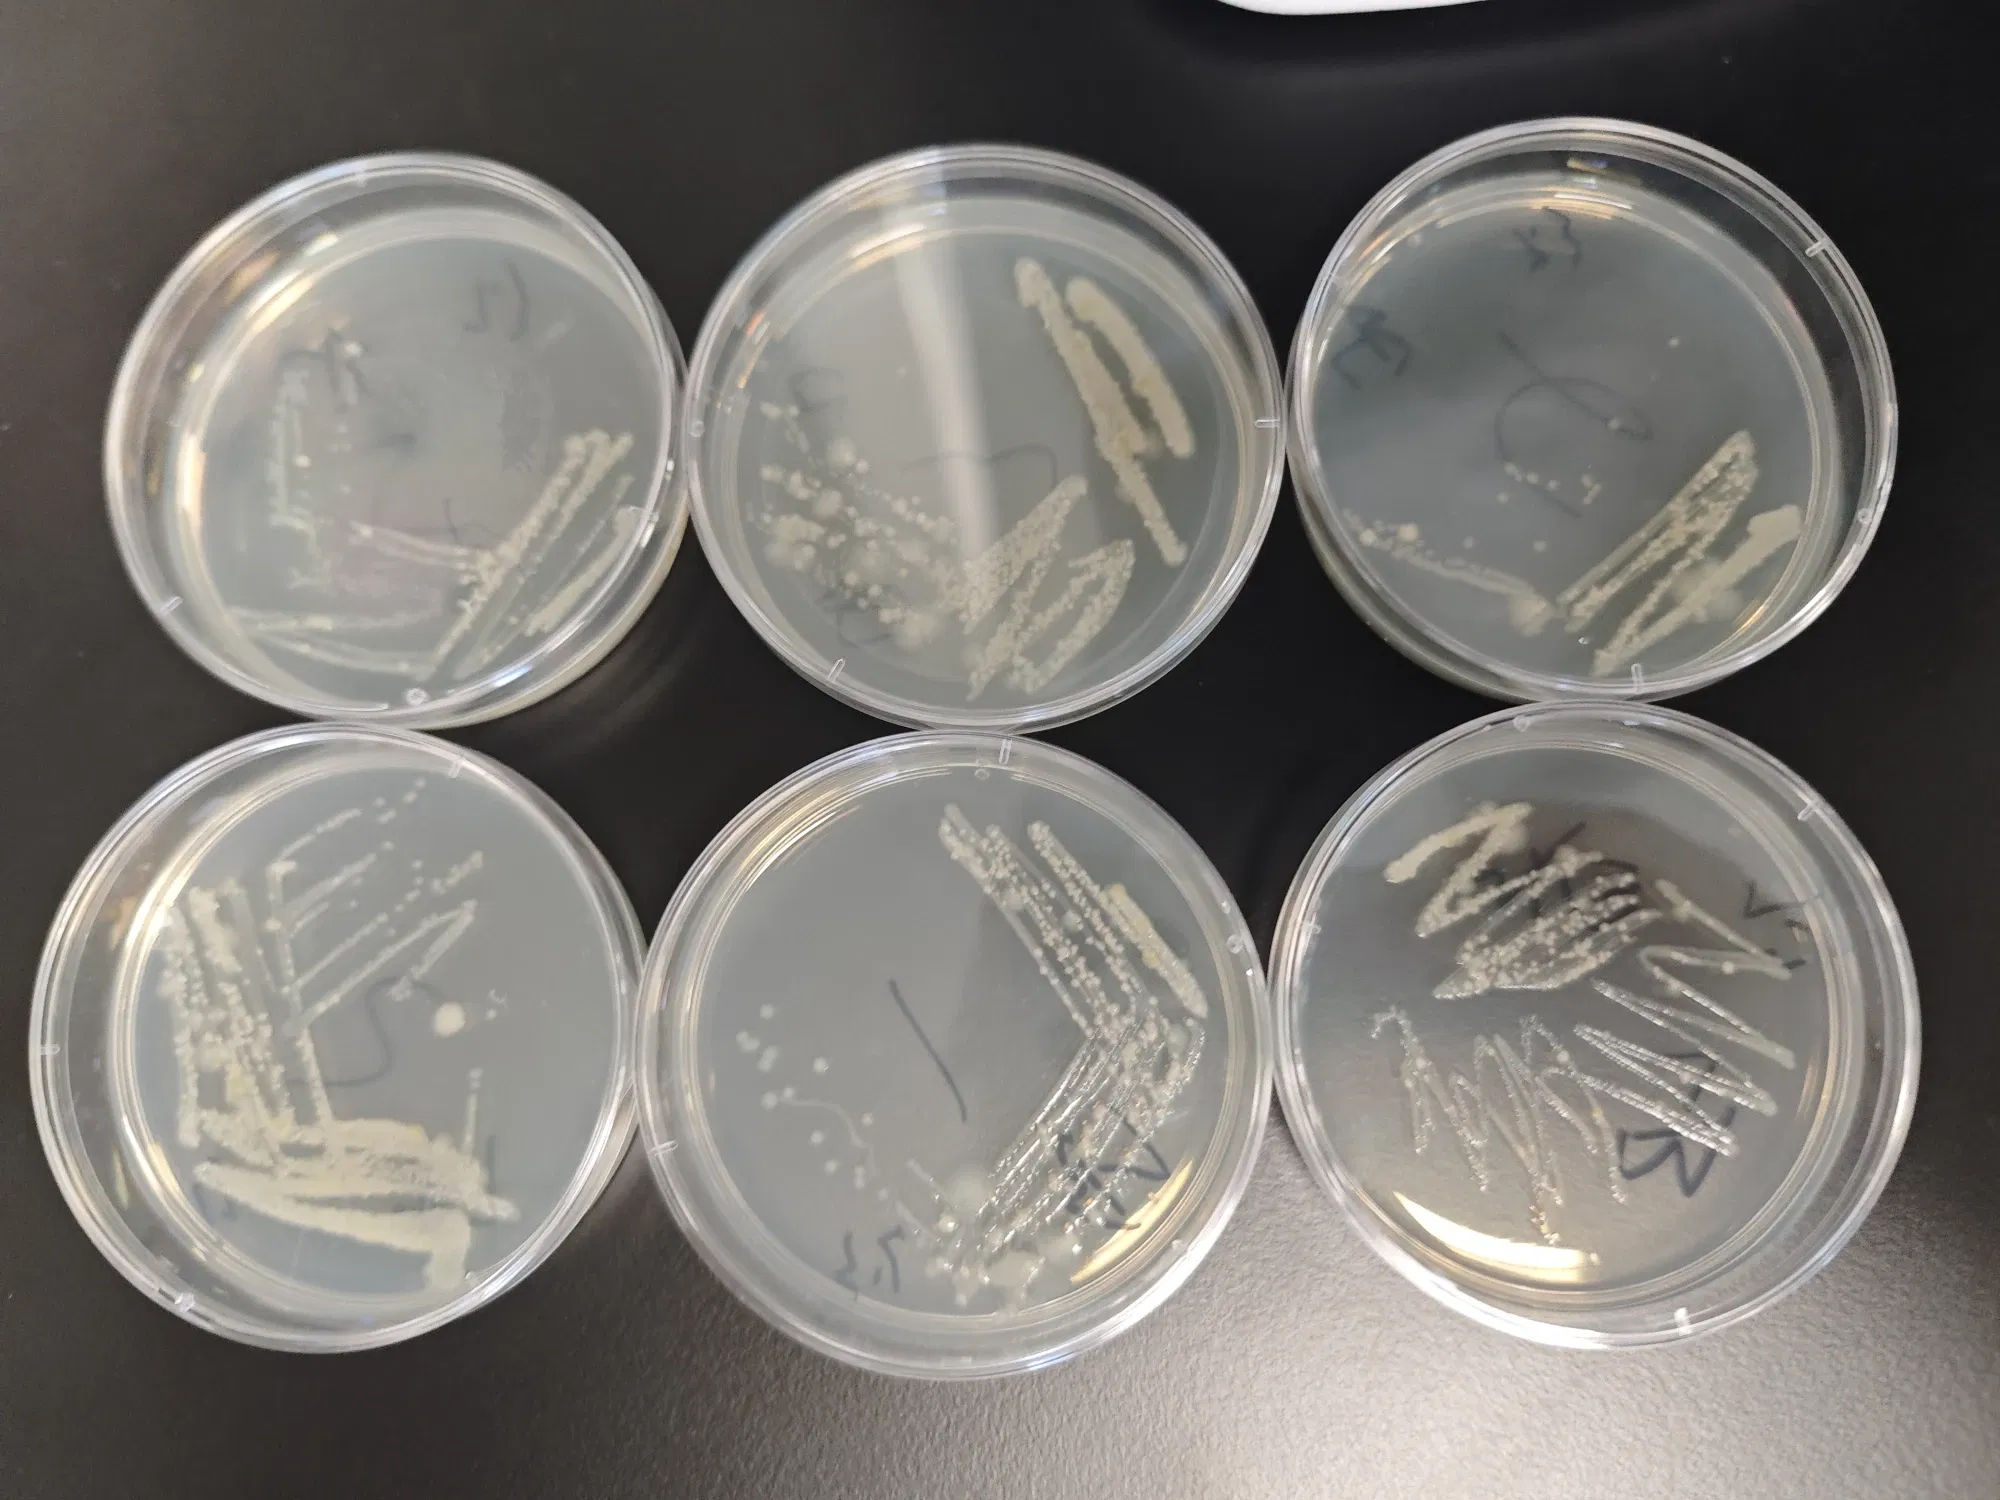
featured

thaliajorah (51)
2 followers27 postsNot following anybody19 HP
Blacklisted UsersMuted UsersFollowed BlacklistsFollowed Muted Lists
Blacklisted UsersMuted UsersFollowed BlacklistsFollowed Muted Lists
Joined July 2025 Active 4 months ago